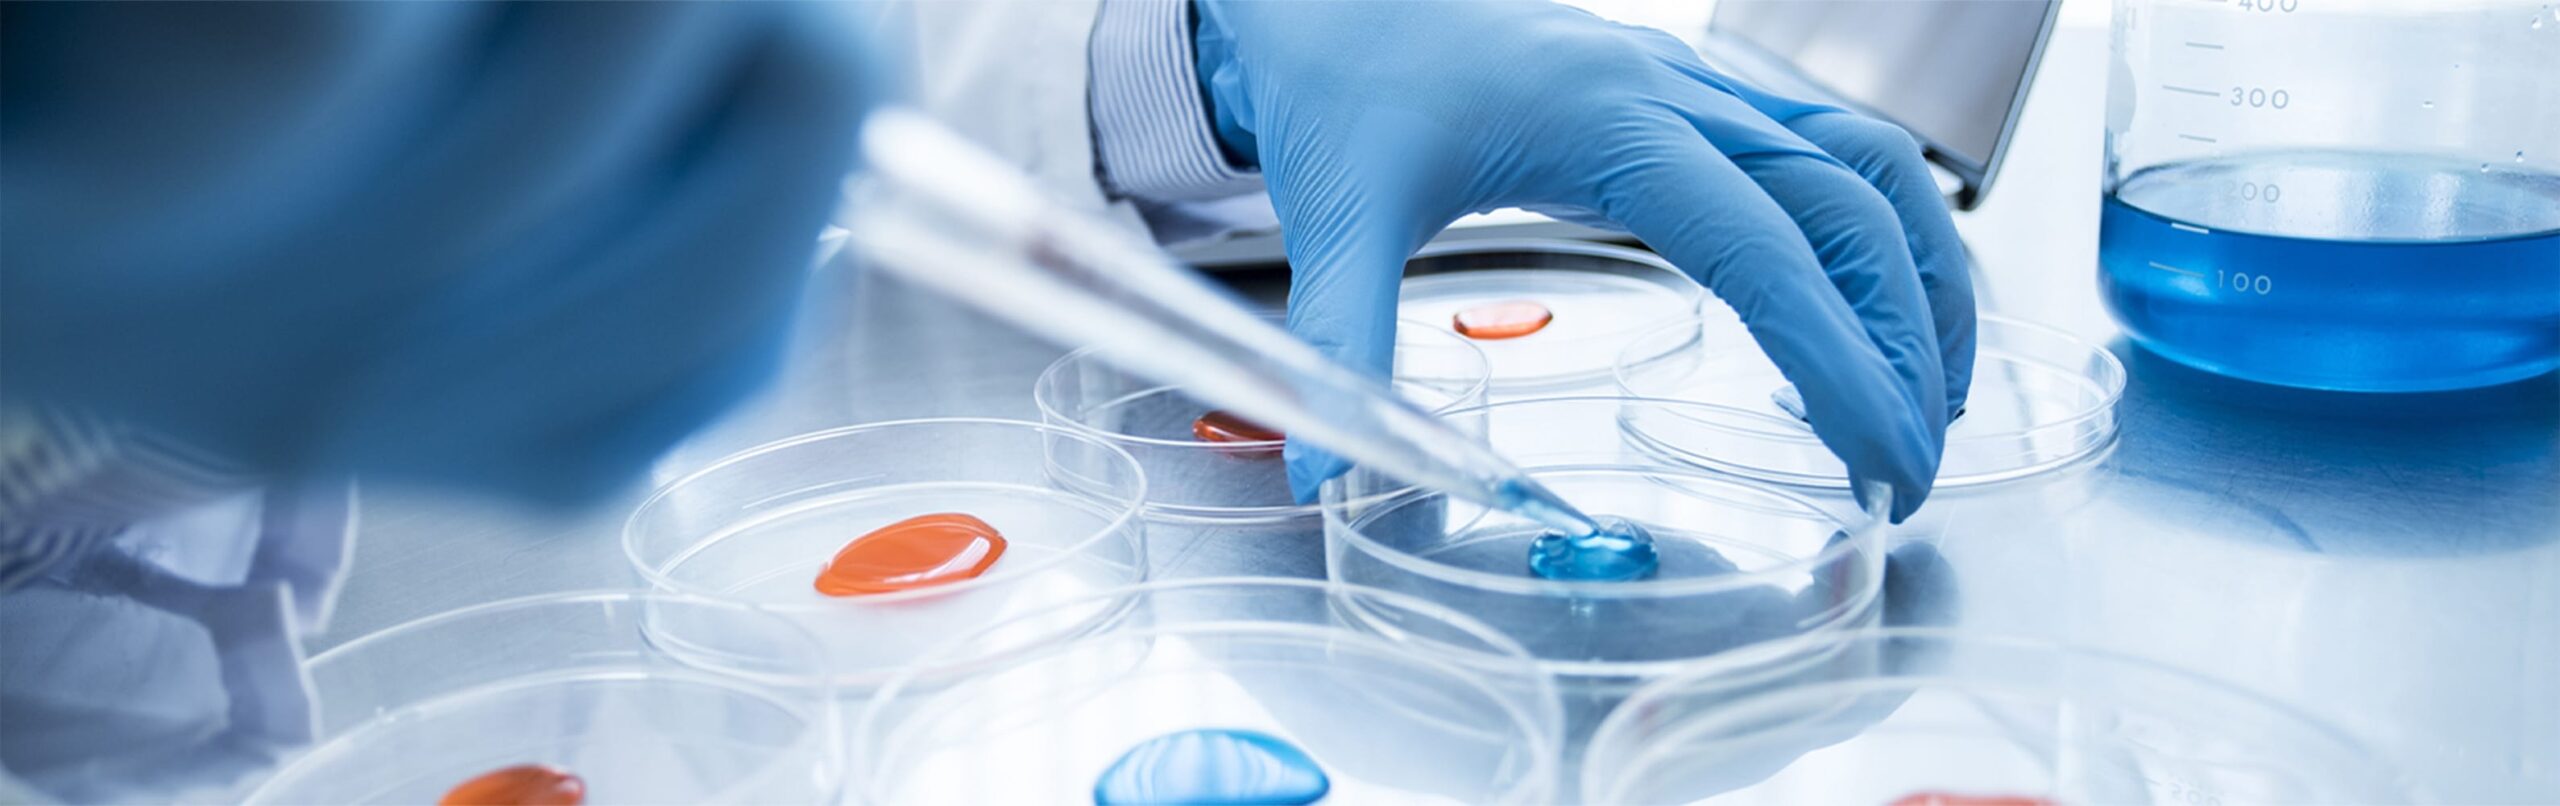

環境方針
基本理念
株式会社 コーガアイソトープ 本社工場は、「地球資源が有限であることを認識し、環境の保護に永続的に配慮していく」ことを重要経営課題のひとつとして捉えます。
そして、企業活動と地球環境との共生を目指して全社員が環境問題に積極的に取り組み、社会の安全と発展に貢献する放射線照射事業者として社会的責任を果たします。
行動方針
コバルト60によるガンマ線照射受託業務を中心とする事業活動を通じ、環境管理活動を行い、地域及び地球環境との共生を目指します。
1.ISO14001のマネジメントシステムにより、経済的、技術的に可能な限り環境問題の継続的改善と環境の保護に努めます。
2.環境側面に関連する法規、条例、地域との協定を順守し、環境の保護に取り組みます。
3.当社が行う事業活動が環境に与える影響の中で、次の項目を重点テーマとして取り組みます。
①ガンマ線照射施設の適切な維持管理を行います。
②低炭素社会実現のため、電力使用効率の向上を図ります。
③希少資源であるコバルト60の利用効率の向上を図ります。
4.生物多様性及び生態系の保護に関する意識をもって、環境活動を推進します。
5.環境教育、環境カードなどで、全社員(役員、社員、契約社員、臨時社員など当社のために働く人)への
環境方針の理解と環境に関する意識向上を図ります。
また、社外一般へ、環境方針を公開し、理解と協力を得ます。
2024年06月01日
株式会社 コーガアイソトープ 代表取締役社長
松山 元彦
環境マネジメントシステム適用範囲
| 名称 | 株式会社コーガアイソトープ 本社工場 |
| 所在地 | 滋賀県甲賀市甲賀町神保53-6 |
| 要員 | 全社員(役員、社員、契約社員、臨時社員など当社のために働く人) |
| 活動範囲 | ガンマ線照射受託、小分け包装作業受託 |



